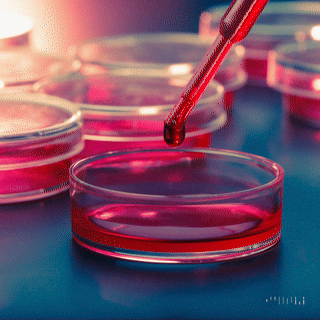

Suero Fetal Bovino Mexicano: Calidad Superior y Eficiencia Nacional
El cultivo celular es esencial para la investigación científica, la biomedicina y la producción farmacéutica. En este contexto, el suero fetal bovino (SFB) es un recurso invaluable, utilizado como suplemento nutritivo que impulsa el crecimiento y proliferación celular. Pero, ¿sabías que el SFB producido en México, especialmente por empresas líderes como B-BIO, no solo reduce los tiempos de entrega sino que además supera en calidad al importado?
¿Qué hace único al Suero Fetal Bovino?
El SFB es una sustancia rica en proteínas, factores de crecimiento, hormonas y nutrientes esenciales obtenida del plasma sanguíneo de fetos bovinos. Se emplea principalmente para apoyar cultivos celulares en investigaciones médicas, biotecnológicas y farmacéuticas, contribuyendo significativamente al desarrollo de vacunas, terapias celulares y estudios científicos de alto nivel.
Ventajas del Suero Fetal Bovino Nacional (México)
Rapidez y Frescura Garantizada
El consumo de productos nacionales implica tiempos de entrega considerablemente más cortos. Al producirse localmente, empresas mexicanas como B-BIO entregan suero que ha sido recientemente procesado, asegurando que la eficacia del producto sea óptima al momento de llegar a los laboratorios e instituciones.
Control Rigurosísimo de Calidad
La industria nacional mexicana destaca por su estricto control de calidad, implementando procesos como filtración estéril (hasta 0.1 μm) y asegurando niveles mínimos de endotoxinas y hemoglobina. Este rigor en la producción posiciona al SFB mexicano como un producto altamente confiable y eficaz en comparación con productos importados cuyos controles pueden variar según el país de origen.
Cumplimiento con Normativas Internacionales
El SFB mexicano no solo cumple sino que frecuentemente supera estándares internacionales de calidad, obteniendo aprobaciones importantes como la del Departamento de Agricultura de Estados Unidos (USDA). Esto brinda un respaldo adicional a investigadores y empresas farmacéuticas sobre la calidad superior del producto nacional.
Comparativa: ¿Por qué elegir B-BIO frente al SFB Importado?
CaracterísticaSuero B-BIO (Nacional)Suero ImportadoEntregaInmediataTardía (aduanas)FrescuraAltaVariableCalidadEstándares estrictosVariableCostosCompetitivosElevados
B-BIO: Compromiso Mexicano con la Excelencia
La marca mexicana B-BIO ha consolidado una sólida reputación al enfocarse en la calidad, frescura y competitividad de su SFB. Su inversión constante en tecnología y estándares internacionales permite ofrecer un producto excepcionalmente confiable, con ventajas claras frente a alternativas extranjeras.
Al preferir productos nacionales como el de B-BIO, no solo optas por excelencia y rapidez en el servicio, también fortaleces la economía local y apoyas el crecimiento de la innovación biotecnológica en México.
Referencias
Biowest. (2025). Suero Fetal Bovino (FBS) México, aprobado por el USDA. Recuperado de https://biowest.net/es/suero-fetal-bovino-fbs-mexico-aprobado-por-el-usda-s1650/
Química Vakmes. (2025). Suero Fetal Bovino Standard 100% Mexicano. Recuperado de https://www.vakmes.com/tienda/p/suero-fetal-bovino-standard
SciELO México. (2023). Caracterización del suero bovino fetal proveniente de la industria. Recuperado de https://www.scielo.org.mx/scielo.php?pid=S2007-11242023000200277&script=sci_arttext&tlng=es